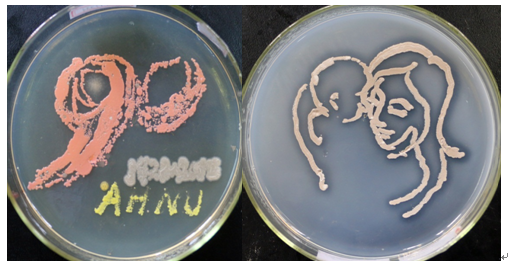
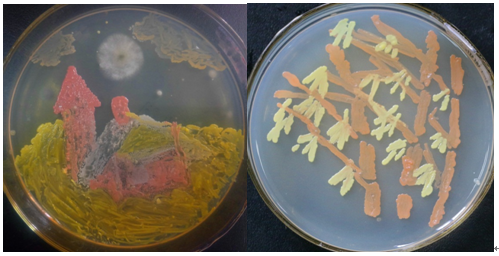
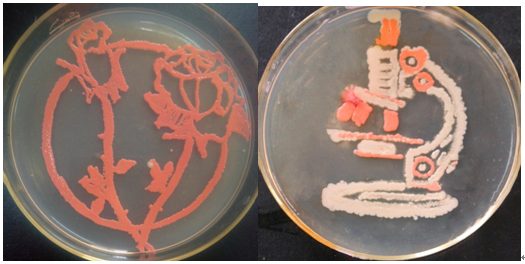

5月16日,由生科院生物技术专业主办、院团委学生会协办的首届微生物培养皿绘画艺术大赛成功举办。生物技术专业负责人刘爱民、杨安娜、汪建中、陆鹏、谢萍等微生物学专业教师担任评委。校内共50支队伍参赛。
参赛选手经过将近一个月的精心调研、准备,细心制作,同时得到相关专业老师的耐心指导,最终提交参赛作品76件,并附说明详细介绍了作品的名称、微生物菌种构成、设计理念、制作过程等,在培养皿的方寸之地彰显了微生物培养的工匠精神,更好地展示了多姿多彩的微生物世界。评委从整体构图造型、色彩搭配、表达展示、微生物培养操作等四个方面进行打分。
刘爱民对本次大赛做总结。她对同学们参赛的积极性、动手能力和作品给予了充分肯定,同时指出,个别作品存在色泽相对单调、所用菌种单一、被外源微生物污染从而破坏构图等不足,希望同学们今后多研究改进,进一步提高实践动手能力。
最终,高杰等同学的作品《喜迎校庆》、汪征等同学的《母亲的爱》获得一等奖;《乡间小屋》、《竹》、《小猪佩奇》获得二等奖;《T4噬菌体》、《芬芳花语》、《生物之眼》、《福》、《樱宁宁》获得三等奖;《一帆风顺》等10件作品获得优秀奖。
喜迎校庆(一等奖)母亲的爱(一等奖)
乡间小屋(二等奖)竹(二等奖)
小猪佩奇(二等奖)T4噬菌体(三等奖)

芬芳花语(三等奖)生物之眼(三等奖)
福(三等奖)樱宁宁(三等奖)

 附:生科院首届微生物培养皿绘画艺术大赛获奖名单.doc
附:生科院首届微生物培养皿绘画艺术大赛获奖名单.doc

